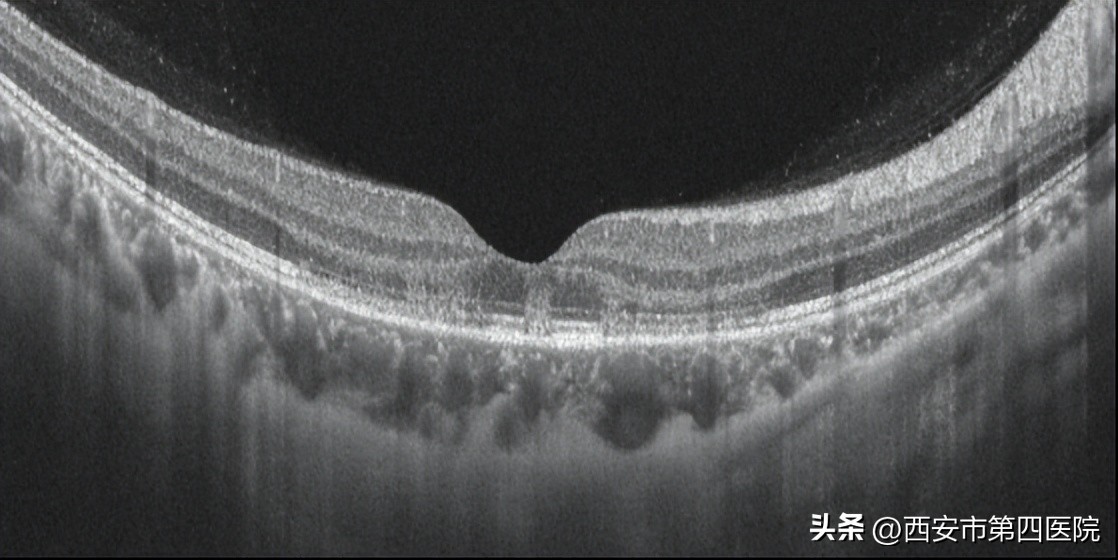
#新冠防疫手册#33岁女士“阳康”后视力下降、模糊、黑影……

“吞刀片”......
“水泥鼻”......
“冰火两重天”......
相信大多数的“小阳人”
都是亲身经历过的
“带入式”体验
伴随着体内“高烧之火”的退去
大家的病情也都会有所好转
01 “身轻如燕”的同时,眼前的模糊仍然没有好转
33岁的陈女士(化名)也不例外,她在经历过这一番并经折磨后终于沉沉地睡去。但是当她一觉醒来,发现身体觉得“轻快”了许多的同时,眼前的世界怎么模糊了许多,似透过磨玻璃?

这个时候的小陈还沉浸在“身轻如燕”的欢快中没有多想,以为是前段时间没有休息好导致的,便补足营养继续休息了。怎料过了几天,眼前的模糊仍然没有好转,陈女士这才急匆匆地赶到西安市人民医院(西安市第四医院)眼影像诊断中心王海燕主任专家门诊就诊。
02 结合检查结果,给予局部激素治疗
经过王海燕主任的追溯追问,陈女士早在一周前就出现咽痛、咳嗽、周身疼痛的症状,当时自行检测新型冠状病毒抗原呈阳性,随后出现发热、乏力症状,体温最高达39.7℃,发热两天后出现双眼视力下降、视物模糊,眼前有黑影遮挡,尤其右眼明显,现在新型冠状病毒抗原检查转阴性了,但眼部症状仍然没有恢复。
王海燕主任立即安排患者做了检查,患者右眼视力0.6,左眼视力1.0,眼压正常,眼底检查和红外(IR)成像发现双眼眼底有“花瓣状”暗红色病灶,尖端指向中心凹


双眼眼底彩照所示: 黄斑区深褐色改变;


双眼红外(IR)成像:所示黄斑区可见“花瓣状”低反射信号,尖端指向中心凹)

双眼眼底OCT检查: 外核层、外丛状层强反射灶,椭圆体带、嵌合体带结构不连续。
OCT检查提示:双眼外核层、外丛状层强反射灶,椭圆体带、嵌合体带结构紊乱,甚至断裂。


双眼OCTA6*6mm检查: 黄斑周围深层毛细血管血流密度降低。
OCTA显示视网膜深层毛细血管网血流密度降低。
结合患者病史及检查结果,王海燕主任诊断陈女士为双眼急性黄斑神经视网膜病变(AMN),给予局部激素治疗,辅以改善循环、营养神经保护治疗。
03 积极治疗,眼前黑影消散了!
其实,对于感染新型冠状病毒的患者而言,陈女士出现的视物模糊、视力下降并非个例。在我国新型冠状病毒眼病防控专家共识(2022年)指出,新冠病毒感染患者出现眼部病变的比例为0-35.71%。新冠病毒的传播途径之一为气溶胶传播,眼球作为暴露在气溶胶环境中的粘膜之一,也是新冠病毒的潜在传播途径。另有研究提示在新冠病毒无症状感染者中眼房水检测到了病毒阳性。诸多研究表明,新冠病毒具有眼部趋向性。
AMN作为一种较为少见的黄斑病变,其发病率在新冠病毒流行期间大量增加。常出现在年轻女性,是视网膜深层毛细血管病变,多表现为黄斑区楔形暗红色病灶,视野旁中心暗点,常常双眼病变不对称。
此外,新冠病毒对眼底的影响不止会造成AMN的发生,还会引起诸如眼底出血、棉绒斑、PAMM征、血管迂曲扩张、动静脉阻塞,视神经炎等,严重者会诱发深度感知下降或视力丧失。
与此同时,还有一位患者是18岁男性,高热后出现双眼视力下降,右侧眼底彩照所示盘斑间、血管弓处大量黄白色棉绒斑;

OCT所示: 外丛状层、外核层高反射灶(AMN征),内核层局灶性高反射信号(PAMM征,白箭)

OCT所示: 神经纤维层和神经节细胞层高反射信号(对应棉绒斑,蓝箭)
经过积极抗炎,抗凝,改善微循环,营养神经治疗,陈女士的眼前黑影消散了,视物模糊的症状也得到了好转。
04 看过来,几点建议送给你!免费的呦~
目前尚无新冠病毒感染眼病的特效药物,所以预防新冠感染后带来的眼部不适,最重要的是平时加强自身防护。这里小编送给大家几点建议:
1、保持社交距离,外出佩戴口罩,注意手卫生,避免手直接接触眼部;

2、去往医院等公共场所时,可佩戴面罩或防护眼镜;

3、居室环境保持清洁,勤开窗,多通风;

4、注意休息,加强营养,提高自身免疫力,毕竟免疫力才是保护我们的第一道屏障!

如果感染新冠后自觉视力下降,
一定要积极就诊哦!
万万不敢大意!